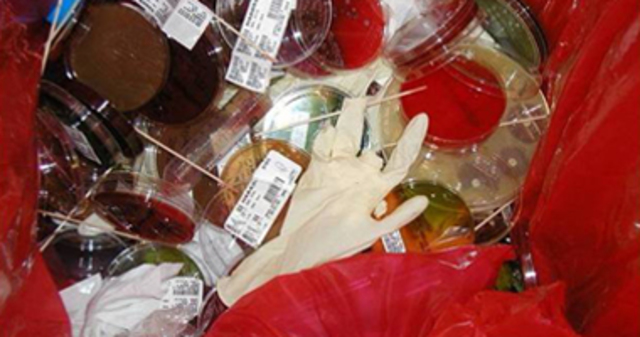
Resolución 1164 de 2002

Marco legal Farmacovigilancia y Tecnovigilancia - Jairo Stiven Reyes Amador - Bogota D.C
By steven reyes
-
Abarca normativas desde 1993 hasta fecha actual
-
El invima reglamenta los reportes sanitarios de los laboratorios farmacéuticos y establecimientos fabricantes de los productos en los cuales se presente complicaciones en los usuarios como eventos adversos, problemas relacionados con el medicamento,eventos adversos fuertes del medicamento un lote mal utilizado estos reportes se hacen para que los usuarios no utilicen esos medicamentos y sean devueltos a sus fabricantes para evitar complicaciones en los usuarios
-
Esta ley regula al químico farmacéutico con el fin de proteger y salvaguardar la seguridad en los procesos de seguridad en los medicamentos,cosméticos,preparaciones farmacéuticas con base productos naturales y demás insumos en la área de la salud relacionados con el campo de la química farmacéutica
-
Reglamente la profesión de tecnología en regencia de farmacia ubicado en la are de la salud cuya formación lo capacita para desarrollar tareas de apoyo y colaboración en la preparación del servicio farmacéutico y en la gestión administrativa de los establecimientos distribución mayoristas y minoristas.Colaborar bajo la dirección del químico farmacéutico en las actividades de suministro de medicamentos y demás insumos en la salud para la realización de formulas magistrales
-
Por el cual se adopta el manual de procedimientos para la gestión integral de los residuos hospitalarios y similares representan un riesgo para la salud del personal es por eso que hay que desecharlos con el mayor de los cuidados para que no se contamine el los dispositivos médicos
-
Tiene como objetivo regular las actividades de los pocesos propios en la ejecución de los servicios farmacéuticos como dispensación,recepción,almacenamiento y las áreas del establecimiento farmacéutico para una mejor ejecución y un mayor control de los procedimientos fundamentales del establecimiento farmacéutico
-
Es un documento en el cual el instituto nacional de vigilancia de medicamentos y alimentos invima reglamenta el registro sanitario para obtener el permiso de comercialización y vigilancia sanitaria de los dispositivos médicos y medicamentos para que sean saludables para el consumo humano. Avalúen su autenticidad en el estado colombiano
-
Es el sistema de salud obligatorio en la atención de la salud y fue creado para mantener y mejorar la calidad de los servicios de salud en Colombia y prestar accesibilidad y lograr una satisfacción para los usuarios que la requieran para mejorar su estilo de vida
-
Se establecen las condiciones que deben ser cumplir los prestadores de servicios de salud para habilitar sus servicios y llevar a cabo el componente de auditoria para el mejoramiento de la calidad en la atención donde se dicta otras disposiciones como recursos humanos,infraestructura , dotación,medicamentos y dispositivos médicos , historias clínicas , referencia de pacientes y seguimiento a riesgo en la prestación de servicios de salud a los usuarios para dar cumplimiento con la norma
-
Es la que determina los procedimientos y criterios de la administración, técnicas generales del modelo de prestación de servicio farmacéutico y adopta condiciones y procedimientos que se exponen en el manual para una mejor planificación y ejecución de los procesos farmacéuticos
-
El objetivo principal es que se reglamente el programa de tecnovigilancia a fin de fortalecer la seguridad de la utilización de dispositivos médicos en las actividades de eventos adversos, factor de riesgo , defectos de calidad , fallas de funcionamiento , riesgos , trazabilidad etc.Con el fin de dar un mayor control de los procedimientos y saber un poco mas sobre las actividades que se desarrollan cada día en el campo de la salud
Plan projects on a visual timeline
Map milestones, phases, deadlines, and key events in one place so the sequence is easier to see and share. Timetoast is a timeline maker for work, school, research, and stories.